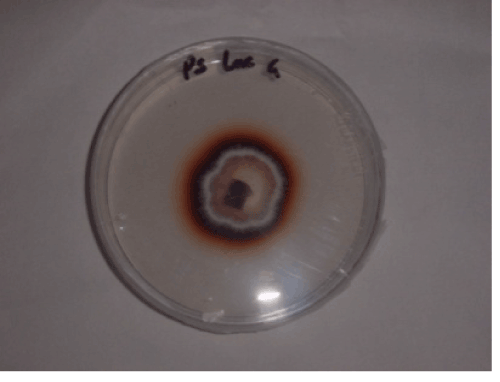

Research Article Open Access
Biodegradation of Reactive Blue 4 and Orange G by Pycnoporus sanguineus Strain Isolated in Gabon
| Atteke Christiane1*, Mounguengui Steeve2,4, Saha Tchinda Jean-Bosco3,4, Ndikontar Maurice Kor3, Ibrahim Brama1, Gelhaye Eric5, Gelhaye Eric5 | |
| 1Université des Sciences et Techniques de Masuku (USTM), BP 901, Gabon | |
| 2Institut de Recherche en Ecologie Tropicale (IRET), BP 13354, Gabon | |
| 3Laboratory of Macromolecular Chemistry, University of Yaounde, Cameroon | |
| 4Laboratoire d’Etude et de Recherche sur le Matériau Bois, Faculté des Sciences et Techniques, Nancy- Université, Bld des Aiguillettes, F-54500 Vandoeuvre-lès-Nancy, France | |
| 5Laboratoire Interactions Arbres/Micro-Organismes, Faculté des Sciences et Techniques, Nancy-Université, Bld des Aiguillettes, F-54500 Vandoeuvre-lès-Nancy, France | |
| Corresponding Author : | Atteke Christiane Université des Sciences et Techniques de Masuku (USTM), BP 901, Gabon Tel: (+241) 07 87 90 27 E-mail: cnkoule@yahoo.fr |
| Received September 25, 2013; Accepted November 04, 2013; Published November 11, 2013 | |
| Citation: Christiane A, Steeve M, Jean-Bosco ST, Kor NM, Brama I, et al.(2013) Biodegradation of Reactive Blue 4 and Orange G by Pycnoporus sanguineus Strain Isolated in Gabon. J Bioremed Biodeg 4:206. doi: 10.4172/2155-6199.1000206 | |
| Copyright: © 2013 Christiane A, et al. This is an open-a ccess article distributed under the terms of the Creative Commons Attribution License, which permits unrestricted use, distribution, and reproduction in any medium, provided the original author and source are credited. | |
Related article at Pubmed Pubmed  Scholar Google Scholar Google |
|
Visit for more related articles at Journal of Bioremediation & Biodegradation
Abstract
The fungus Pycnoporus sanguineus MUCL 51321 white rot isolated in Gabon showed a high ability to decolorize and degrade two synthetic dyes. On solid and liquid media, the fungus had different enzyme activities (laccase and manganese (Mn) peroxidase) in the presence of different substrates. At concentrations of 0.05 g/L (Orange G) and 0.3 g/L (reactive blue 4), the respective rates of decolorization of 81% and 97% were observed after 15 days of incubation in liquid media. In the same time interval, changes on the spectra (UV-vis and FTIR) and chromatograms (HPLC) showed that these decolorizations were due to the degradation of dyes by fungus with the production of new compounds. The study revealed the possibility of the use of this fungal strain in the microbial degradation process of synthetic dyes.
| Keywords |
| Pycnoporus sanguineus MUCL 51321; Biodegradation; Orange G; Reactive blue 4; Laccase; Mn peroxidise; Gabon |
| Introduction |
| A large number of synthetic dyes with specific chemical groups (azo, acid, base, anthracene, triphenylmethane etc.) are widely used in the textile, cosmetic, and pharmaceutical industry [1]. In addition, a significant amount of these compounds, are discharged into the environment through effluents [2]. Such dyes as reactive blue 4 (RB4) and Orange G with anthracene and azo functional groups respectively are widely used in the textile industry. These compounds are classified as recalcitrant to degradation and hazardous to the environment as well for aquatic wildlife and flora [3,4]. Different methods such as adsorption, precipitation, oxidation, reduction etc. are used for the elimination of these compounds [1]. During disposal, different toxic products can be generated and evacuated through effluents into the environment. Alternative treatment methods, using bacteria or fungi (energy efficient and economical), are currently widely studied [1,5]. Enzymes from certain fungi (laccase, lignin peroxidases and manganese peroxidases) have shown a high ability of degradation of synthetic dyes [3,6]. Physicochemical parameters of the culture medium (pH, concentration, temperature etc.) as well as the fungal type, affect the decolorization of dyes. It is in this context that many studies have been interested in the optimization of the physicochemical parameters of the medium for new strains with high degradation abilities [7-9]. The Pycnoporus sanguineus (P. sanguineus) fungus is known for its ability to degrade lignin and synthetic molecules using ligninolytic enzymes [10-12]. Studies have shown that dyes such as the RB4 and Orange G can be degraded by fungi such as T. versicolor, P. sordida, T. lauteus and P. flabellatus [5,13]. In addition, using analytical methods such as FTIR, UV-Vis and HPLC authors have monitoring the decolorization and microbial degradation [14-16]. The present study reports the ability of the P. sanguineus MUCL 51321 fungus to decolour and degrade two recalcitrant synthetic dyes (RB4 and Orange G). Some operational culture medium parameters were optimized to achieve maximum dyes decolorization, using enzymes some of which activities were evaluated. Additionally, intermediates formed during degradation, were observed by HPLC and FTIR. |
| Materials and Methods |
| Microorganisms |
| The P. sanguineus MUCL 51321 fungus was collected from wood parks in Gabon and sent by Dr. Cony Decock a mycology specialist (Brussels mycothèque, Belgium) who conditioned and replicated them in tubes containing the medium malt-agar at 25°C. These tubes were then preserved and maintained at 4°C before use. |
| Dyes and chemicals |
| The two dyes reactive blue 4 and Orange G were obtained from Sigma-Aldrich (Sigma-Aldrich Chimie sarl, Saint Quentin Fallavier, France); agar powder and malt extract from Acros Organics (Fisher Scientific SAS, Strasbourg, France); ABTS (acid, 2, 2-azino-bis (3-ethylbenzothiazoline)-6-sulfonic acid), TFA (trifluoroacetic acid) and ethyl acetate were obtained from Sigma-Aldrich (Sigma-Aldrich, St. Louis, MO, USA). Methanol for HPLC was obtained from Carlo Erba Réactifs (Carlo Erba Reactifs-SDS, Val de Reuil, France). Glucose was obtained from Prolabo (VWR International S.A.S, Strasbourg, France). All minerals to culture media were obtained from Sigma-Aldrich (Sigma-Aldrich, St. Louis, MO, USA). All reagents used were of the analytical grade. |
| Culture Conditions |
| The composition of the solid growth medium used was as follows: 0.2% glucose, 0.2% malt extract, 0.01% MgSO4, 0.01% MnCl2, 0.03% NH4NO3, 0.026% KH2PO4, 0.026% Na2HPO4, 0.01% CaCl2.2H2O, 0.0001% FeC13.6H2O, 0.0001% ZnCl2, 1.6% and 1.6% agar in 1 L of distilled water. The pH was adjusted to 5.5 with hydrochloric acid (0. 5 N) before autoclaving (at 121°C for 15 min). The culture medium was transferred into 4 Erlenmeyer flasks (200 mL each) and each reagent (enzymatic revelation) or dye, depending on its final concentration was added. The mixture was shaken, then about 15 mL were distributed in a Petri dish (diameter 8.5 mm); each test was replicated three times. 50 mL of liquid culture media in flasks of 100 mL were constituted in almost the same way as the solid culture media described above, except for the absence of agar. Each test was conducted three times. |
| Decolorization experiments |
| Dyes decolorization on solid medium: Solid culture media contained different concentrations of each dye (0.05 g/L to 1.5 g/L). Various controls were also prepared: some Petri dishes with fungus alone and others with dye alone to assess possible abiotic decolorization. One square portion of agar (1 cm of diameter) containing the fungus was placed at the centre of each Petri dish. The fungal growth diameters and the halos of decolorization were measured every day during one week at constants temperature (30°C) and humidity (75%). After these measures, different ratios and rates (decolorization or inhibition) were determined as described by Sánchez-López et al. [17]. The optimum temperature of decolorization was evaluated using different growth temperatures (15, 22, 30, 35, 40 and 45°C). Moreover, the optimal concentrations for decolorization (0.05 g/L for the Orange G and 0.3 g/L for the RB4) were obtained after one week. All tests were conducted three times (averages are presented with the corresponding standard deviations). |
| Dyes decolorization on liquid culture medium: For each Erlenmeyer flask (100 mL) containing liquid culture medium (50 mL) and dye (0.05 g/L Orange G or 0.3 g/L of RB4), one disc of agar of 1 cm diameter containing the fungus was added under sterile conditions. Different culture media were incubated for 15 days at 35°C in static conditions. Erlenmeyer flasks controls were also prepared (dye alone or fungus alone in culture medium). Every 3, 6, 9, 12 and 15 days, Erlenmeyer flasks were removed to evaluate the activities of laccase and Mn peroxidase, as well as the rate of decolorization of the culture media. Then each culture media was centrifuged at 40000 rpm for 15 minutes using an Eppendorf 5702 centrifuge (Eppendorf France S.A.S, Le Pecq, France) to separate the supernatant and mycelium. The decolorization of culture media was evaluated by measuring the maximum absorbance at 478 nm for the Orange G and 596 nm for the RB4, of 3 mL of each supernatant liquid using a UV-Vis (Varian) Cary Scan spectrophotometer (Varian, Inc., Palo Alto, USA). The percentage decolorization was calculated according to the formula: |
 |
| Absorbance of control is absorbance of the initial synthetic dye solution that was equal to 0% of decolorization and constant throughout the study. |
| Ligninolytic enzymatic activities on solid medium |
| Laccase activity: The method described by Mishra et al. [8] has been slightly modified to characterize the presence of laccase activity on the solid medium. The solid culture medium contained 0.01% (w/v) of guaiacol (orthomethoxy phenol). It was autoclaved (at 121°C for 15 min) and 5×5 mm2 of agar containing the fungus was placed at the centre of a Petri dish after cooling. After a few days, a red coloration appeared around the colony, indicating the presence of laccase. |
| Phenoloxidase activity: As previously stated, a piece of agar with the fungus was put in a Petri dish containing the solid culture medium and 0.5% of gallic acid was added. The appearance of a brown area around the colony after 3 days indicates the presence of polyphenol oxidases [18]. |
| Peroxidase activity: Peroxidase activity was evaluated by the method described by Pointing [18] using ABTS (0.1%) and 0.5% H2O2. |
| Ligninolytic enzymatic activity on liquid medium |
| Enzyme activities were measured in various supernatants in the absence of mycelium at the rate of 3 trials for each point. The laccase activity was measured using the method based on the oxidation of ABTS and the measurement of absorbance using a UV-Vis (Varian) Cary Scan Spectrophotometer at 420 nm [19]. Lignin peroxidase (LiP) activity was measured by monitoring the oxidation of veratryl alcohol at 310 nm using the method by Tien and Kirk [20]. Manganese peroxidase (MnP) activity was measured according to the method using phenol red at 610 nm in the presence of Mn2+ [19]. All enzymatic reactions were conducted at 30°C. Ligninolytic enzymatic activity was expressed as U per mL of supernatant extracted (U/mL). One unit of enzyme activity U was defined as the amount that catalysed the production of one micromole of substrate per minute per milliliter of reaction mixture. |
| Procedure of degradation products extraction |
| One part of supernatant liquid (10 mL) obtained after decolorization and centrifugation with an Eppendorf 5702 centrifuge was extracted 4 times using ethyl acetate at different dates (0, 3, 6, 9, 11 and 15 days). Organic phases were grouped in different Eppendorf tubes before be evaporated under vacuum using Univapo 150 H centrifuge evaporator (UniEquip GmbH, Martinsried/Munich, Germany). The same procedure was used for control culture media (fungus alone in medium). Dry residues obtained, consisting of degradation products of dyes and fungal secondary metabolites, were frozen to -4°C prior to all analyses. |
| FTIR and HPLC Analysis |
| The dye biodegradation was characterized by FTIR using a Perkin Elmer 2000 spectrometer (PerkinElmer, Street Waltham Massachusetts, USA). Different spectra were compared across the 400-4000 cm-1region. Each dry residue (test or control sample) was mixed with KBr (5:95) prior to analysis. HPLC analyses were performed using the hardware described by Mounguengui et al. [21] and analyzed using the software Empower between 200-800 nm. The measurements were obtained with a Supelco Discovery C18 (250 mm x 4,6 mm i.d.) column (Sigma-Aldrich Chimie sarl, Saint Quentin Fallavier, France) at 30°C and a mobile phase at the rate of 1.5 mL min-1. The separation of compounds was performed using distilled water containing 0.05% TFA and methanol containing 0.05% TFA with a gradual program. Methanol was used at 52% for 5 minutes and increased to 70% during 10 minutes. It was then increased to 95% for 25 minutes and then decreased to 52% for 2 minutes. The dyes and solid residues containing different degradation products were dissolved in 1 mL of methanol prior to injection. |
| Statistical analysis |
| Data are expressed as mean and standard deviation. Statistical comparisons between different measurements (growth rate, decolorization, inhibition and enzymatic activities) were performed using analysis of variance (ANOVA) according by Tukey-Kramer comparison with software Kaleidagraph 4.0 test. p<0.05 was considered as statistically significant. |
| Results and Discussion |
| Effect of concentration and temperature on dyes decolorization |
| Monitoring of the synthetic dyes (RB4 and Orange G) decolorization led to the optimization of certain physicochemical parameters as concentration and temperature on solid medium. The pH (5.5) used in this study was retained as the optimum pH for decolorization of the two dyes. Solid culture media with different concentrations of dye (0.05; 0.1; 0.2; 0.3 and 1.5 g/L) were used. The results showed a significant decrease of decolorization with increasing dye concentration, as well as very important differences between the two dyes at the same concentrations (Figure 1). In literature, the concentrations usually used are less than 0.2 g/L [4,9,22-24]. In this study, a concentration of 0.3 g/L of RB4 was optimal with a decolorization rate of 98%. In addition for these samples, the rate of inhibition, decolorization and growth of 7.6 ± 2%; 0.44 ± 0.1 (cm/day) and 1.84 ± 0.5 (cm/day) respectively, were observed. But at this concentration (0.3 g/L), it seems to be difficult for fungus to degrade Orange G (Figure 1); it would appear that this concentration can be toxic to fungus. Rates of inhibition, decolorization and growth of Orange G of 34.8 ± 1.5%; 0.21 ± 0.01 (cm/day) and 1.26 ± 0.02 (cm/ day) respectively were observed. For these different values, p<0.05. For Orange G dye, it would be preferable to use the concentration of 0.05 g/L with which the decolorization rate was greater than 99%. With concentrations of 0.05 and 0.1 g/L, rates of decolorization of RB4 were very close (p<0.05), unlike for Orange G at the same concentrations, decolorization rates were very different (p>0.05). |
| The concentration of the dyes influences their elimination by fungi from a combination of different factors such as toxicity at high concentrations and ease of recognition of substrates by enzymes at low concentrations of dyes [25]. |
| Temperature was varied from 15°C to 45°C in order to determine the optimal temperature of decolorization of the two dyes (Figure 2). Maximum decolorization was observed at 35°C for the two dyes. At this temperature, RB4 has a rate of decolorization of 95.1% and Orange G a rate of 91%. It is nevertheless important to show that between 30 and 40°C, the decolorization rates were superior to 80%. These values with can be explained by the thermo-tolerance of the fungus P. sanguineus as described by Dantan-González et al. [26], as well as its ability to degrade many recalcitrant compounds [9]. |
| Decolorization and enzyme activities on liquid media |
| After 15 days growth in liquid medium, decolorizations of approximately 97% of the RB4 and 81% for the Orange G (Figure 3) were observed. These two values show that this fungus decoloured the RB4 dye better. Similar results [27] shown the difficulty for the I. lacteus fungus to eliminate mono or diazo dyes such as Orange G compared to anthraquinone dyes such as RB4. For a period of 18 days exposure, Rigas and Dritsa obtained rates decolorization of poly R-478 (100 mg/L) of 93.4% by G. australe, 66.25% by P. ostreatus sp.3 and 98.49% by P. sanguineus respectively [23]. Some of these values were similar to those obtained during this study despite a higher concentration and a shorter time (15 days). This shows that the present strain of P. sanguineus has a strong ability to degrade these dyes studied. |
| The inserts in Figure 3 represent UV-Vis (280 nm-700 nm) spectra of the supernatant samples at different times (0, 8 and 15 days). A decrease of the maximum absorbance is observed (478 nm for Orange G) and (594 nm for RB4) during the incubation period, reflecting a very strong capacity of dye degradation by this fungus. Elsewhere, by changing the composition of the medium, Eichlerova et al. [28] showed that fungi D. squalens, I. resinosum and P. calyptratus significantly degrade Orange G and Remazol Brilliant Blue in two weeks at the concentration of 500 mg/L. The reduction of absorbance areas of the chromophores translates a decrease in absorbance and therefore in colour. Although the duration of 15 days seems to be important, it should be noted that the concentration used for the RB4 is higher than those usually used for this type of test (0.05 g/L-0.2 g/L). Therefore this fungus could be economically interesting in future biotechnological applications. |
| Various enzyme activities were highlighted in the presence of substrate on solid culture medium (Table 1). The activities presented in this study were already observed with other strains of P. sanguineus [9,26]. Laccase activity was observed using guaiacol as a substrate. After 3 days of growth, a reddish-brown coloration around the colony, indicating activity laccase (Figure 4). This coloration is due to polymerization by oxidation of guaiacol in the presence of laccase. |
| Production of ligninolytic enzymes by P. sanguineus on liquid medium, containing the dye or not, was followed as a function of time (Figure 5). No lignin peroxidase activity was observed. Low laccase (Lac) and manganese peroxidase (MnP) activities were observed in the control media (without dye). Maximum laccase activities were observed after 3 days of incubation with values of 5.05 ± 0.2 U/mL and 2, 48 ± 0.1 U/mL in culture media with RB4 and Orange G respectively. There is a significant difference between these two values (p < 0.05). |
| For the same observation period (3 days), MnP activity was maximum in the presence of RB4 (1.18 ± 0.02 U/mL). The same activity was maximum after 6 days in presence of Orange G (0.59 ± 0.01 U/mL) with a significant difference between the two values (p<0.05). These enzymatic activities are known to be observed during the degradation of many dyes [9,29,30]. In this study, laccase activity is predominant compared to the MnP activity. According to Valderrama et al. [31], |
| the fungal-enzyme system involved in dye decolorization generally presentes a large amount of laccases compared from other ligninolytic enzymes. After 6 days of incubation in culture media, more than 50% decolorization was observed (Figure 3). Arantes and Milagres [29] shows the presence of laccase activity in culture media containing Azure B during different incubation periods with L. edodes 0.2 U/ mL (15 days), with P. medullapanis 0.2 U/mL (30 days) and with T. versicolor 0.4 U/mL (17days). Laccase activity has also been reported to be responsible for decolorization of Orange G by I. rasinasum and P. calyptratus [32]. However, in our study, enzymatic activities (Lac and MnP) during the incubation period (15 days), suggest that these enzymes were heavily involved in the decolorization of the two dyes. |
| Analysis of degradation products by FTIR and HPLC |
| The two dyes, as well as their degradation products were analyzed by FTIR and HPLC and the results are presented in Figure 6 and 7. Figures 6a-6d were respectively spectra FTIR of RB4 control, the RB4 sample degraded, Orange G control and Orange G sample degraded. Figure 6a (RB4 control) presented a great peak to 3442.87 cm-1 representing -NH- and hydroxyl (-OH) extensions. The peaks at 1616.78 cm-1, 1545.96 cm-1 and 1411.98 cm-1 are those of the aromatic ring (C=C). The peaks located between 1287.13 cm-1 and 1118.54 cm-1 are those C-N extensions. Peaks to 1031.14 cm-1, 682.52 cm-1 and 618.45 cm-1 are those respectively of the sulfonic groups (S=O) and the -C-S- vibration. Finally, the peaks between 794.57 cm-1 and 730.06 cm-1 are those of the C-Cl extensions. The spectrum of RB4 degradation products (Figure 6b) showed the disappearance of various peaks such as the sulfonic groups (at 618.45 cm-1) as well as those of the aromatic rings (at 1545.96 cm-1 and 1411.98 cm-1). At the same time, there were the appearance of peaks at 1636.03 cm-1 and 1384.39 cm-1 corresponding respectively to C=O deformations of acids and aldehydes and C-O vibration of acids. |
| In addition to these changes, there were an increase in the peak at 2918.20 cm-1 attributed to asymmetric vibrations of the methyl and methylene groups. The comparison of the FTIR spectra of Orange G (control) (Figure 6c) and degradation products (Figure 6d) showed an increase of the peaks at 2918.04 cm-1 and 2851.54 cm-1 attributed to formation of methyl and methylene groups. The disappearance of azo peak (1494.18 cm-1) during decolorization showed a degradation of the original Orange G into amines with the presence of large peak to 3440.46 cm-1 representing amines and phenolic groups. There were also the disappearance of C=C bonds at the peaks 1555.25 cm-1 and 1415.45 cm-1, as well as the C-N bonds (1278.59 cm-1; 1202.28 cm-1 and 1144.87 cm-1). Finally, Figure 6d showed also the disappearance of sulfonic functions (1049.36 cm-1 and 1034.44 cm-1). Different authors have also shown similar changes during the biodegradation of certain azo and anthraquinone dyes [14-16]. |
| Figures 7a and 7b show 3D chromatograms (HPLC) of the RB4 control and degradation products by P. sanguineus respectively. Figure 7b showed all peaks with retention times below three minutes, as well as absorbance areas exceeding 400 nm. These observations were different from those of Figure 7a (RB4 control) with retention times between 2 and 6 minutes (1.8, 2.5 and 5.3 min), as well as absorbance areas above 600 nm. Figures 7c and 7d showed 3D chromatograms (HPLC) of the Orange G (control) and degradation products by P. sanguineus respectively. |
| Figure 7d showed several peaks at 3.4 min, 6.4 min, 8.5 min, 7.6 min and 16.1 min and the absorbance areas between 280 and 350 nm. These observations were completely different from those in Figure 7c (Orange G control) with two peaks at 3.1 min and 3.9 min and absorbance beyond 500 nm. Similar results were presented during a HPLC follow-up of dye biodegradation [14-33]. The FTIR spectrum as well as the chromatogram of control (fungi alone) (not presented) were different from those of the degradation products (Figure 6b, 6d, 7b and 7d). According to the analytical data (FTIR and HPLC), it is clear that during the exposure of the P. sanguineus MUCL 51321 fungus on liquid culture medium containing the dyes (RB4 and Orange G), there was degradation of initial dyes as well as the formation of new compounds. |
| Conclusion |
| The present study suggests that the P. sanguineus MUCL 51321 fungus was able to degrade two dyes used in textiles industries at different concentrations. This fungus discolours better at 35°C while producing different enzymatic activities of which the most important is the laccase activity. These results, as well as the high rate of decolorization above 80%, indicate the possible use of this fungus in biotechnological applications. The evaluation of the toxicity of the degradation products and their identification would permit a better analysis and understanding of the degradation processes of dyes by this fungus. |
| Acknowledgements |
| Mounguengui Steeve, on behalf of the other authors, is grateful to the International for Tropical Timber Organization (ITTO) for the financial assistance (award of Research Fellowship). |
References
|
Tables and Figures at a glance
| Table 1 |
Figures at a glance
 |
 |
 |
|
| Figure 1 | Figure 2 | Figure 3 | Figure 4 |
 |
 |
 |
| Figure 5 | Figure 6 | Figure 7 |
Relevant Topics
- Anaerobic Biodegradation
- Biodegradable Balloons
- Biodegradable Confetti
- Biodegradable Diapers
- Biodegradable Plastics
- Biodegradable Sunscreen
- Biodegradation
- Bioremediation Bacteria
- Bioremediation Oil Spills
- Bioremediation Plants
- Bioremediation Products
- Ex Situ Bioremediation
- Heavy Metal Bioremediation
- In Situ Bioremediation
- Mycoremediation
- Non Biodegradable
- Phytoremediation
- Sewage Water Treatment
- Soil Bioremediation
- Types of Upwelling
- Waste Degredation
- Xenobiotics
Recommended Journals
Article Tools
Article Usage
- Total views: 14159
- [From(publication date):
August-2013 - Dec 22, 2025] - Breakdown by view type
- HTML page views : 9445
- PDF downloads : 4714
